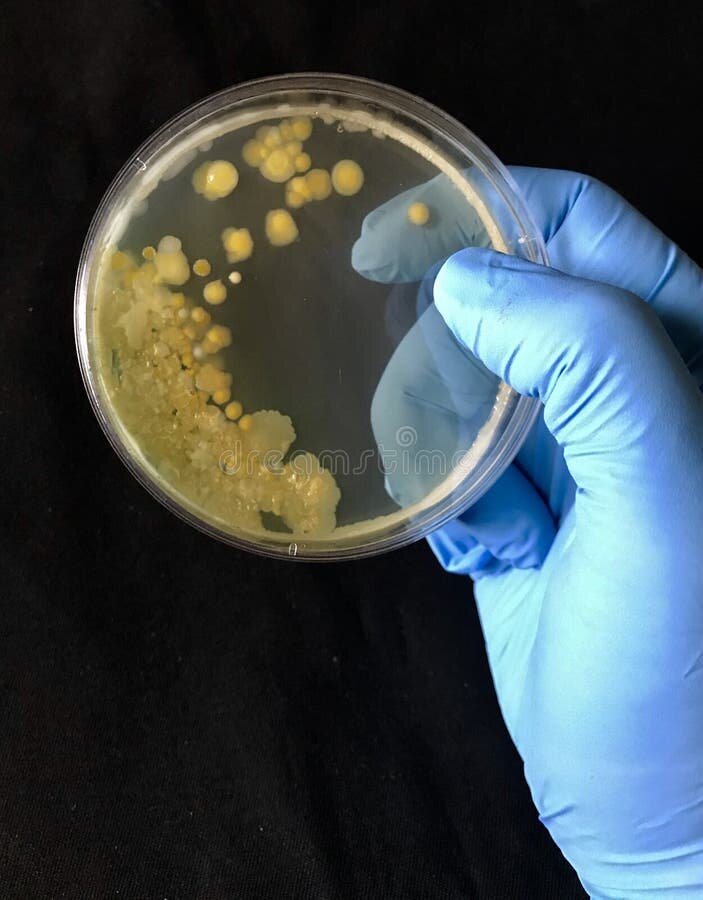
Es un indicio de contaminación bacteriana, propio de un producto que se ha estropeado por falta de frescura o mala conservación.

Cuidado con estas sardinas que venden en España: algunas latas contienen histamina

Es un indicio de contaminación bacteriana, propio de un producto que se ha estropeado por falta de frescura o mala conservación.

Que Agencia Española de Seguridad Alimentaria (AESAN) ha recibido una notificación de la presencia de histamina en una semiconserva de pescado, en particular sardinas ahumadas en aceite de girasoladvierte el Organización de Consumidores y Usuarios (OCU).
No es la primera vez que la histamina está detrás de una advertencia de seguridad alimentaria: La histamina es una sustancia que se encuentra en ciertos alimentos, como B. pescado azul, se forma debido al crecimiento excesivo de bacterias. la presencia de histamina Es un indicio de contaminación bacteriana. Característica de un producto que se ha deteriorado por falta de frescura o mala conservación.
¿Cuál es el producto afectado?
se trata de la Sardinas ahumadas en aceite de girasol de la marca Menú Serie Oro.
Es un producto de origen marroquí, una semiconserva que necesitan mantenerse refrigerados.
Se han identificado problemas en el lote L202CEB0 234 60, que tiene como fecha preferente de consumo el 21/01/2023.
Así lo señalan las autoridades sanitarias que este producto ha sido distribuido en varias comunidades autónomas, destaca en Andalucía, Castilla-La Mancha, Cantabria, Castilla y León, Madrid y Comunidad Valenciana, aunque podría haber llegado a más lugares.
El problema ya ha sido reportado. sacar estas sardinas del mercado.
Si tienes este producto en casa, las sardinas ahumadas en aceite de girasol El Menú Serie Oro del lote indicado, no consumirlo y llevarlo al punto de venta.
Noticias similares
Felizmente No se conocen casos de afectados en España para el consumo, pero comer un pescado con altos niveles de histamina puede producir síntomas similares a una reacción alérgica, lo que puede ser muy peligroso.
Si nota síntomas como hinchazón de la cara o el cuello, Comezón, dolor de cabeza, sensación de ahogo, malestar, etc., busque atención médica lo antes posible después de consumir este producto.
Si quieres conocer otros artículos parecidos a Cuidado con estas sardinas que venden en España: algunas latas contienen histamina puedes visitar la categoría Castilla y León.
Deja una respuesta
Lo siento, debes estar conectado para publicar un comentario.

Otras noticias parecidas